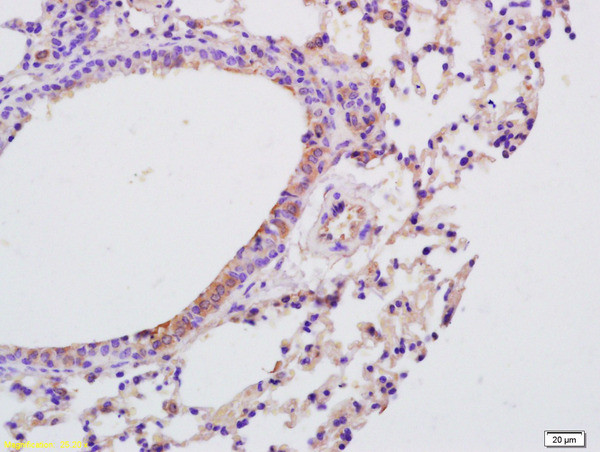
IL-9 Antibody in Immunohistochemistry (Paraffin) (IHC (P))

Search
Bioss
IL-9 Polyclonal Antibody
{{$productOrderCtrl.translations['antibody.pdp.commerceCard.promotion.promotions']}}
{{$productOrderCtrl.translations['antibody.pdp.commerceCard.promotion.viewpromo']}}
{{$productOrderCtrl.translations['antibody.pdp.commerceCard.promotion.promocode']}}: {{promo.promoCode}} {{promo.promoTitle}} {{promo.promoDescription}}. {{$productOrderCtrl.translations['antibody.pdp.commerceCard.promotion.learnmore']}}
产品信息
BS-2428R
种属反应
宿主/亚型
分类
类型
抗原
偶联物
形式
浓度
规格
纯化类型
保存液
内含物
保存条件
运输条件
靶标信息
Interleukin 9 (IL-9) is produced by activated T helper 2 (Th2) lymphocytes. IL-9 regulates many cell types involved in classical Th2-associated asthma responses, including B and T lymphocytes, mast cells, eosinophils, and epithelial cells. The mouse IL-9 cDNA encodes a 144 amino acid precursor protein with an 18 amino acid signal peptide that is cleaved to form the mature cysteine-rich protein with a molecular mass of 14 kDa. Native mouse IL-9 is heavily glycosylated. Recently, TGF beta has been reported to play an important role in the differentiation of IL-17-producing T helper cells and inducible regulatory T cells by reprogramming Th2 cells to secrete IL-9, thereby driving the differentiation of Th9 cells directly.
仅用于科研。不用于诊断过程。未经明确授权不得转售。
篇参考文献 (0)
生物信息学
蛋白别名: Cytokine P40; IL-9; ILN; Interleukin; Interleukin-9; Interleukin9; T-cell growth factor P40
基因别名: Il-9; Il9; P40
UniProt ID: (Mouse) P15247
Entrez Gene ID: (Mouse) 16198, (Rat) 116558